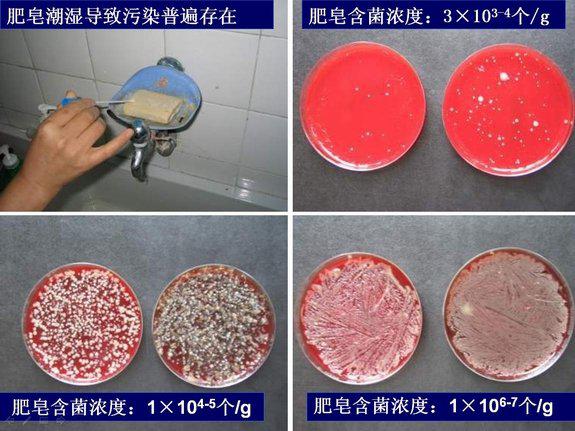

手卫生真的有那么重要吗? 一个人身体上的细菌数超过全中国的人口数,一名医务人员手部的菌落数量约为3.9×104-4.6×106。患者皮肤上有很多医院相关性病原体。医院感染病原体不仅可以从感染的或渗出的伤口获得,还可以从正常、完整的患者皮肤细菌定植获得。会阴或腹股沟区域是细菌定植最多的区域。微生物如金黄色葡萄球菌、奇异变形杆菌、克雷伯菌属和不动杆菌属在某些患者完整皮肤定植的数量为100-160cfu/cm2。患者周围环境也有很多医院相关性病原体,每天有近106个带有病原体的皮屑会从正常皮肤脱落,患者的衣物、床单、床边的家具和其它周围环境都会被细菌污染。
医院感染中90%为接触性传播,医护人员的手为病原菌传播的重要媒介,因为众多纷繁的医疗护理操作需要手来完成。
手卫生是一种简单、低成本的行为,目前在全球范围内被公认为是一种减少外源性医院感染和控制耐药菌传播的首要方法。国外有研究表明,30~40%耐药菌感染是由于手卫生不当所致,而通过加强手卫生可降低30%的医院感染。手卫生并不是一种可有可无的选择,提高手卫生依从性能够显著加强患者的医疗安全,它是解决医护人员手污染、预防和控制病原菌传播、降低医院感染率的重要手段。
什么是手卫生?什么是手消毒剂?
◆手卫生:为医务人员洗手、卫生手消毒和外科手消毒的总称。
◆洗手 :医务人员用肥皂(皂液)和流动水洗手,去除手部皮肤污垢、碎屑和部分致病菌的过程。
◆卫生手消毒:医务人员用速干手消毒剂揉搓双手,以减少手部暂居菌的过程。
◆外科手消毒 :外科手术前医务人员用肥皂(皂液)和流动水洗手,再用手消毒剂清除或者杀灭手部暂居菌和减少常居菌的过程。使用的手消毒剂可具有持续抗菌活性。
◆手消毒剂:用于手部皮肤消毒,以减少手部皮肤细菌的消毒剂,如乙醇、异丙醇、氯己定、碘伏等。
◆速干手消毒剂:含有醇类和护肤成分的手消毒剂。包括水剂、凝胶和泡沫型。
◆免冲洗手消毒剂:主要用于外科手消毒,消毒后不需用水冲洗的手消毒剂。包括水剂、凝胶和泡沫型。
什么叫常居菌和暂居菌?哪个和院内感染关系密切?
◆常居菌:能从大部分人体皮肤上分离出来的微生物,是皮肤上持久的固有寄居菌,不易被机械的摩擦清除。如凝固酶阴性葡萄球菌、棒状杆菌类、丙酸菌属、不动杆菌属等。一般情况下不致病。
◆暂居菌:寄居在皮肤表层,常规洗手容易被清除的微生物。直接接触患者或被污染的物体表面时可获得,可随时通过手传播,与医院感染密切相关。
您会正确洗手吗? 洗手看似简单,却大有学问。许多人在洗手时,只是简单快速的搓洗一下手心、手背,就以为已经完成任务,而下图所示的阴影部分往往会被遗漏。正确的洗手应遵循以下步骤:

如果您使用流动水+皂液洗手:




如果您的水龙头不是非手触式的,在关水龙头时,请记得冲洗水龙头,并用擦手纸巾包裹关闭开关,以避免双手洗净之后又再次污染。此外,洗手前最好脱下手表或戒指,这些部分容易藏污纳垢。擦手一定不要用公用毛巾或工作服,应使用个人专用毛巾、一次性纸巾擦干或用干手器烘干。万一身边缺乏毛巾或纸巾,又没有干手器,自动“风干”也不错。
何时应该洗手? ◆《医务人员手卫生规范》(2009年12月1日实施)中关于洗手的指征:
1、直接接触每个患者前后,从同一患者身体的污染部位移动到清洁部位时;
2、接触患者粘膜、破损皮肤或伤口前后,接触患者的血液、体液、分泌物、排泄物、伤口敷料等之后;
3、穿脱隔离衣前后,摘手套后;
4、进行无菌操作、接触清洁、无菌物品之前;
5、接触患者周围环境及物品后;
6、处理药物或配餐前。
小提示:如果您的手部没有肉眼可见污染时,在以上6种情况下,也可以使用快速手消毒剂,而且建议最好使用快速手消毒剂。
◆WHO提出的手卫生“5个重要时刻”: 请您记住二前三后、把好五关。
二前:接触患者前、行无菌操作前;
三后:体液暴露后、接触患者后、接触患者周围环境后
◆卫生手消毒的指征: a) 接触患者的血液、体液和分泌物以及被传染性致病微生物污染的物品后。
b) 直接为传染病患者进行检查、治疗、护理或处理传染患者污物之后。
小提示:用快速手消毒剂揉搓时保证手消毒剂完全覆盖手部皮肤,直至手部干燥。
用什么进行手卫生? ◆普通手清洗剂――非常有效!可以清除手上绝大多数细菌。(液体皂较固体皂为佳,一次性瓶装比分装皂液更好)
◆快速手消毒剂――理想产品!可以更好的清除手上的细菌,并且非常方便。但需注意,如果手部有可见污渍时不应使用。
◆快速手消毒剂优点:
• 比洗手有更高的依从性
• 比普通洗手和用抗菌产品
洗手更有效
• 比洗手对手部皮肤伤害少
• 比洗手和戴手套浪费少
• 所用时间少,作用快、不需要水和毛巾。
在病区和诊室,建议您停用固体肥皂!
什么是手卫生设施?有哪些要求?
◆手卫生设施是指用于洗手与手消毒的设施,包括洗手池、水龙头、流动水、清洁剂、干手用品、手消毒剂等。
◆手术室、产房、新生儿室等重点部位应配备非手触式水龙头。
◆肥皂应保持清洁与干燥。盛放皂液的容器宜为一次性使用,重复使用的容器应每周清洁与消毒。皂液有浑浊或变色时及时更换,并清洁、消毒容器。
◆手卫生设施的设置应方便医务人员使用。
◆卫生手消毒剂应符合下列要求:
1、应符合国家有关规定。
2、宜使用一次性包装。
3、医务人员对选用的手消毒剂应有良好的接受性,手消毒剂无异味、无刺激性等。
◆外科手消毒设施应达到以下要求:
1、洗手池设置在手术间附近,水池大小、高矮适宜,能防止洗手水溅出,池面应光滑无死角易于清洁。洗手池应每日清洁与消毒。
2、 洗手池及水龙头的数量应根据手术间的数量设置,水龙头数量应不少于手术间的数量,水龙头开关应为非手触式。
3、手消毒剂应取得卫生部卫生许可批件,有效期内使用。
4、应配备清洁指甲用品;可配备手卫生的揉搓用品。如配备手刷,刷毛应柔软,并定期检查,及时剔除不合格手刷。
5、手消毒剂的出液器应采用非手触式。消毒剂宜采用一次性包装,重复使用的消毒剂容器应每周清洁与消毒。
6、应配备干手物品。干手巾应每人一用,用后清洁、灭菌;盛装消毒巾的容器应每次清洗、灭菌。
7、应配备计时装置、洗手流程及说明图。
进行手消毒后应达到什么要求?
根据《医务人员手卫生规范》要求:
◆卫生手消毒,监测的细菌菌落总数应≤10cfu/ cm2。
◆外科手消毒,监测的细菌菌落总数应≤5cfu/cm2。
手卫生应遵循哪些原则?
◆洗手与卫生手消毒应遵循的原则:
a)当手部有血液或其他体液等肉眼可见的污染时,应用肥皂(皂液)和流动水洗手。
b)手部没有肉眼可见污染时, 宜使用速干手消毒剂消毒双手代替洗手。
◆外科手消毒应遵循的原则
a)先洗手,后消毒。
b)不同患者手术之间、手套破损或手被污染时,应重新进行外科手消毒。
小提示:“应”的意思是“必须如此”,“宜”的意思是“适宜如此”,一定要注意这个原则。
戴手套和手卫生能相互代替吗?
有人认为洗手不方便,而采用戴手套代替洗手的方式。根据美国感染控制和流行病协会 (APIC)的调查,有很多关于手套质量的可变性报道:乙烯手套(薄膜手套)有4%一63%、橡胶手套有3%-52%的不可见渗透,另一方面是使用者可能在摘手套时无意中污染了手部。也就是说戴手套不能完全屏蔽病原微生物,不能充分地保护工作人员,也不能充分防止交叉感染,摘下手套后要立即洗手。
手卫生主要是为了去除手部病原微生物的污染,然而,当接触血液、体液或破损粘膜、皮肤时应戴手套,以预防医护人员的职业暴露。
由此可见,手卫生和戴手套不能相互代替,应根据具体情况进行选择。
 上一条: 霍山县中医院“加强手卫生管理”活动方案
上一条: 霍山县中医院“加强手卫生管理”活动方案
